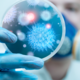
Enfermedades bacterianas

-
 El primer reporte de la existencia de información genética heredable. Debido a su trabajo con guisantes se reconoció que los genes eran responsables de la transmisión de características hereditarias.
El primer reporte de la existencia de información genética heredable. Debido a su trabajo con guisantes se reconoció que los genes eran responsables de la transmisión de características hereditarias. -
 La palabra "gen" es acuñada a partir de una palabra griega que significa "generar", refiriéndose a la unidad física y funcional de la herencia biológica.
La palabra "gen" es acuñada a partir de una palabra griega que significa "generar", refiriéndose a la unidad física y funcional de la herencia biológica. -
 Se realizaron los primeros experimentos de cristalografía de rayos X.
Se realizaron los primeros experimentos de cristalografía de rayos X. -
 Se propuso por primera vez el modelo tetranucleótido plano.
Se propuso por primera vez el modelo tetranucleótido plano. -
 Se demostró que era posible cristalizar macromoléculas, lo que permitió el estudio más preciso de las proteínas y el ADN.
Se demostró que era posible cristalizar macromoléculas, lo que permitió el estudio más preciso de las proteínas y el ADN. -
 Se acuñó por primera vez el término de biología molecular, enfocándose principalmente en el estudio de las macromoléculas.
Se acuñó por primera vez el término de biología molecular, enfocándose principalmente en el estudio de las macromoléculas. -
 Se demostró que el ADN era responsable de la transmisión de caracteres hereditarios en organismos vivos y no las proteínas.
Se demostró que el ADN era responsable de la transmisión de caracteres hereditarios en organismos vivos y no las proteínas. -
 Se dieron a conocer las leyes de Chargaff, que mencionan la complementariedad de las bases nitrogenadas, así como aspectos de composición y proporción que aplican al ADN.
Se dieron a conocer las leyes de Chargaff, que mencionan la complementariedad de las bases nitrogenadas, así como aspectos de composición y proporción que aplican al ADN.
El modelo de Levene queda desacreditado y se necesita una nueva estructura. -
 Se publicó la estructura de la hélice α (alfa) de las proteínas utilizando datos cristalográficos.
Se publicó la estructura de la hélice α (alfa) de las proteínas utilizando datos cristalográficos. -
 Se publicó el modelo de la doble hélice del ADN.
Se publicó el modelo de la doble hélice del ADN. -
 Se obtuvo la primera secuencia de aminoácidos de una proteína: la insulina.
Se obtuvo la primera secuencia de aminoácidos de una proteína: la insulina. -
 Se propuso el dogma central de la biología molecular, el cual afirma que el ADN contiene instrucciones para crear proteínas, las cuales se copian en el ARN.
Se propuso el dogma central de la biología molecular, el cual afirma que el ADN contiene instrucciones para crear proteínas, las cuales se copian en el ARN. -
 Supuso la confirmación de la biología molecular como un área de conocimiento e investigación independiente.
Supuso la confirmación de la biología molecular como un área de conocimiento e investigación independiente. -
 Basados en la colinealidad entre las secuencias de aminoácidos en las proteínas y ADN, se descifró la primera de estas propiedades, el código genético.
Basados en la colinealidad entre las secuencias de aminoácidos en las proteínas y ADN, se descifró la primera de estas propiedades, el código genético. -
 Se descubrieron las enzimas de restricción en la bacteria E. coli.
Se descubrieron las enzimas de restricción en la bacteria E. coli. -
 Se demostró que la transcriptasa reversa, una enzima que se encuentra en los retrovirus, permitía que el ARN copiara al ADN.
Se demostró que la transcriptasa reversa, una enzima que se encuentra en los retrovirus, permitía que el ARN copiara al ADN. -
 Se creó la primera molécula de ADN recombinante.
Se creó la primera molécula de ADN recombinante. -
 Se describió la secuenciación química del ADN.
Se describió la secuenciación química del ADN. -
 Describió una técnica que vuelve a revolucionar la investigación en la biología molecular. Se trata de la reacción en cadena de la polimerasa (PCR).
Describió una técnica que vuelve a revolucionar la investigación en la biología molecular. Se trata de la reacción en cadena de la polimerasa (PCR). -
 Se desarrolló la técnica RLFP (polimorfismo en la longitud de los fragmentos de restricción) que permite detectar fragmentos de ADN de diferentes longitudes.
Se desarrolló la técnica RLFP (polimorfismo en la longitud de los fragmentos de restricción) que permite detectar fragmentos de ADN de diferentes longitudes. -
 Se presentó el primer microchip de genes, también llamado matriz o microordenamiento de ADN (ADN array).
Se presentó el primer microchip de genes, también llamado matriz o microordenamiento de ADN (ADN array). -
 Nace el primer mamífero clonado a partir de una célula adulta.
Nace el primer mamífero clonado a partir de una célula adulta. -
 Se publica el primer borrador del Proyecto Genoma Humano.
Se publica el primer borrador del Proyecto Genoma Humano. -
 Se completó definitivamente la secuenciación del genoma humano.
Se completó definitivamente la secuenciación del genoma humano.
Plan projects on a visual timeline
Map milestones, phases, deadlines, and key events in one place so the sequence is easier to see and share. Timetoast is a timeline maker for work, school, research, and stories.